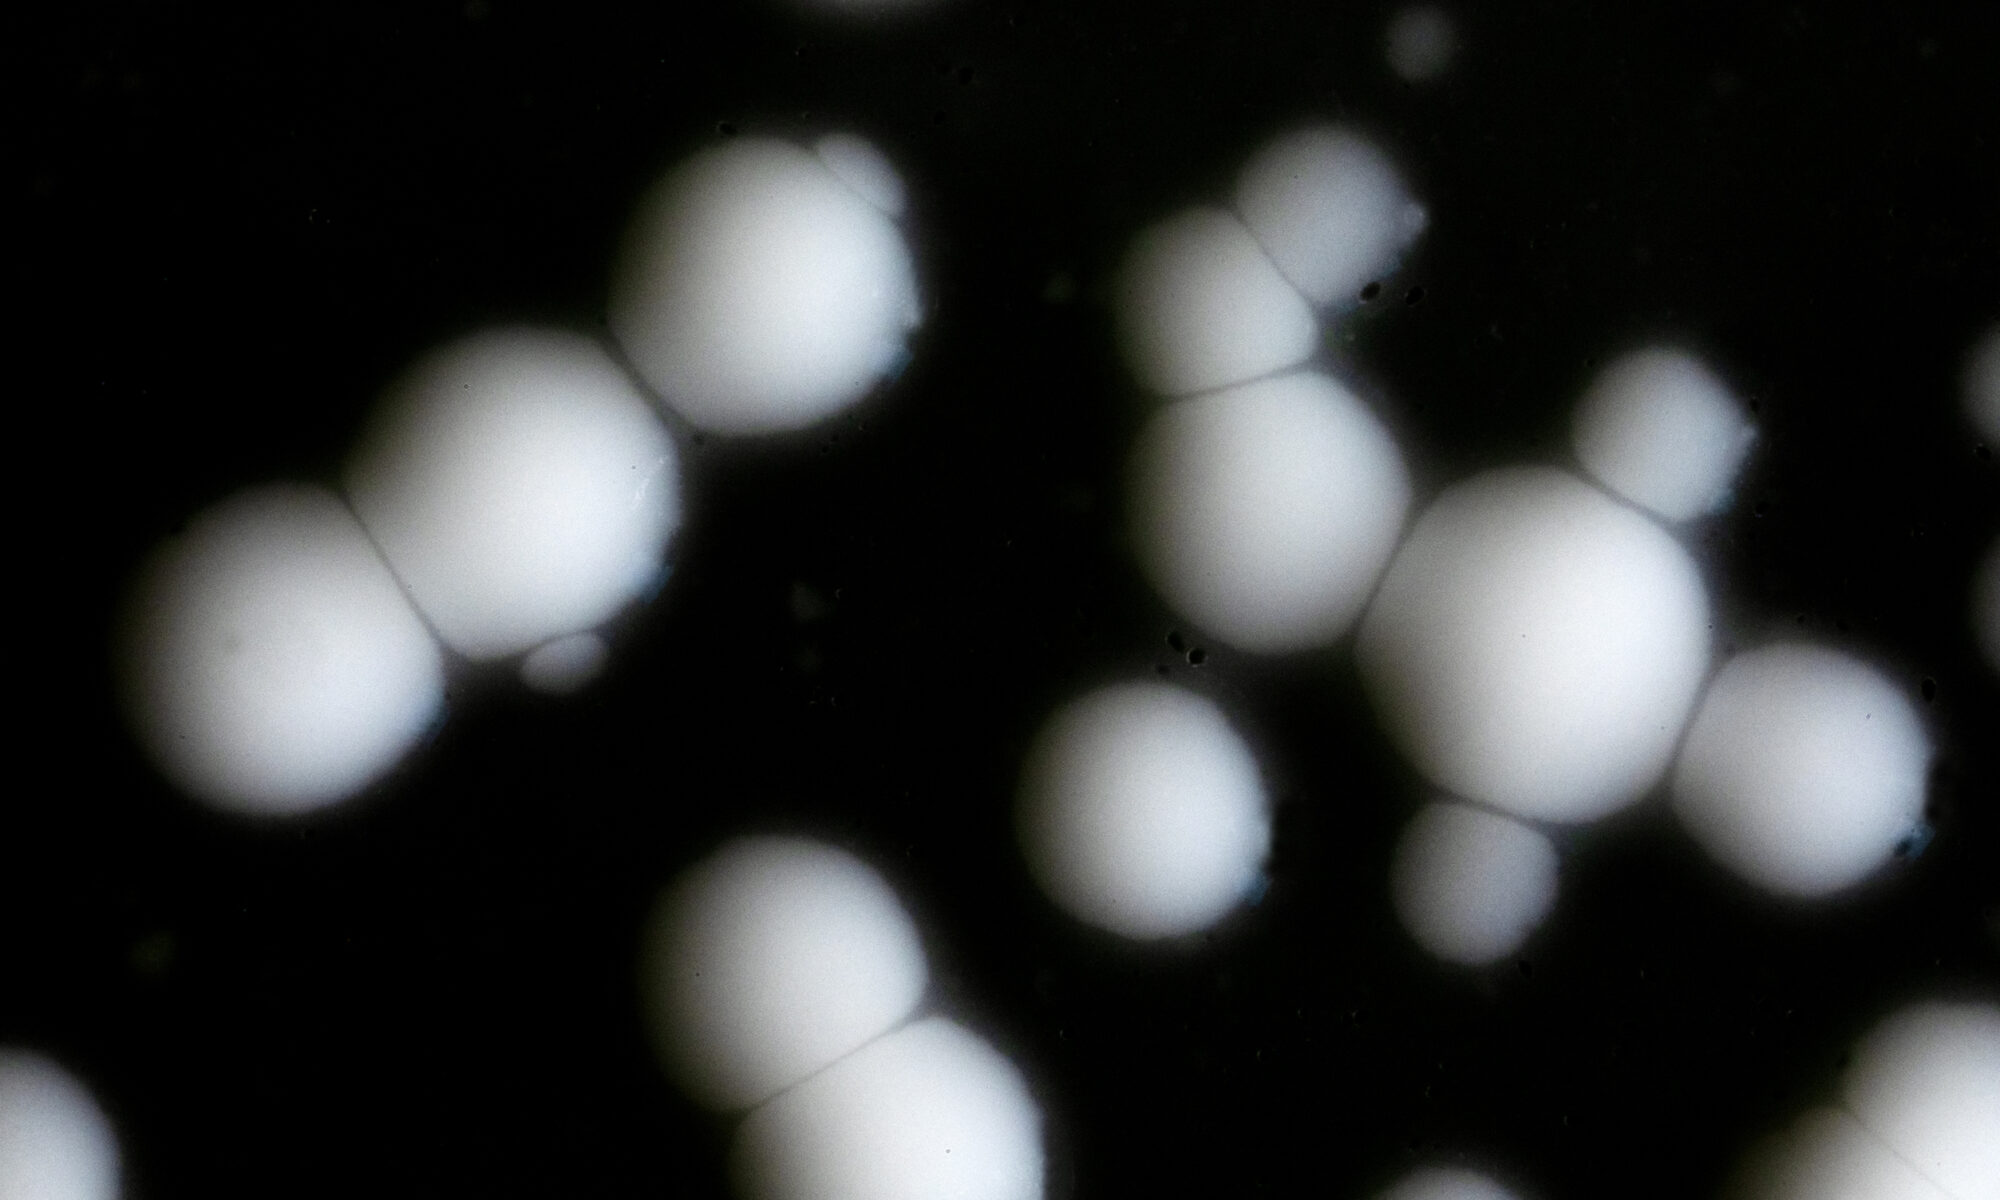

Photo portfolio 2024
The photos are compiled for the grant application photo portfolio.
________
Kuvat koottu apurahahakemuksen kuvaportfoliota varten.
RHIZOMES // MICROBES // YEASTS
The photos are compiled for the grant application photo portfolio.
________
Kuvat koottu apurahahakemuksen kuvaportfoliota varten.